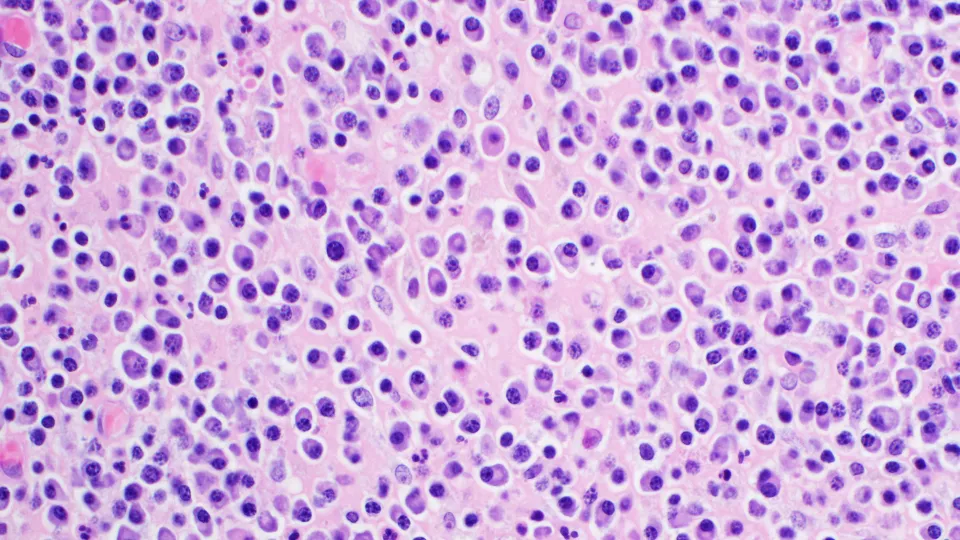

Search Results
-
-
-
-
News Brief
Keisuke Ito, M.D., Ph.D., Named Member of American Society for Clinical Investigation
March 4, 2026
-
-
-
News Brief
Breakthrough Discovery Overturns Long-Held Belief About Blood Stem Cells
September 3, 2025
-
-
-
News Brief
Study Identifies Biomarker that Predicts Response to Anemia Drug for Patients with MDS
June 18, 2025
-
-
-
-
-
-
-
-
-
-
-
-
-
-
-
-
-
-
-
-
-
-
-
-
-
-
-
-
-
-